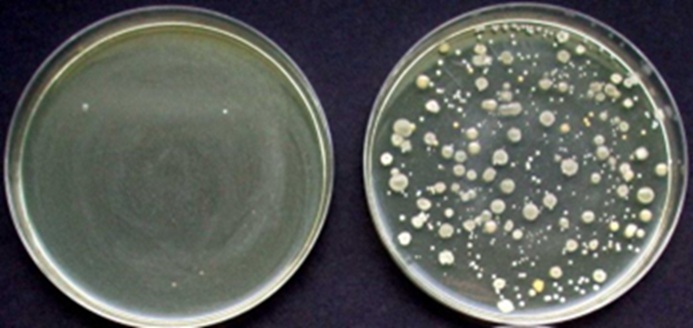

ねずしとは
「ねずし」(写真1)とは、塩蔵したマスの切り身を大根・人参等の野菜類、飯米と共に発酵促進の目的で“米麹”を添加して漬け込むことを特徴とした「いずし」の一種である。歩荷と称される荷担ぎ商人が北陸の塩蔵魚(ブリ,イカ,マス, サバ等)を売り込む際に製法が伝播され、一カ月ほど寝かせてから食すため“ねずし(寝ずし)”と呼ばれるようになったようである。岐阜県飛騨地方から奥美濃地域では、雪に閉ざされる「冬季の保存食」や「正月を祝うためのご馳走」として伝統的に食べ継がれてきた。なお、塩マスは伝統的には富山湾で漁獲されたサクラマスが使われたようであるが、現在ではカラフトマスがほとんどである。
)写真①.jpg)
主な生産地
岐阜県(下呂市、郡上市、高山市、飛騨市)
生産・消費の動向
酸味料などを一切使用せず、自然発酵に頼る製法が採られてきたこともあり、手間暇を掛けても上手くできる保証がないため、自家用としてはほとんど作られなくなっている。一方、岐阜県食品科学研究所で開発した乳酸菌発酵スターターを用いた製品(詳細は後述する)は、その嗜好性や安全性など品質面での安定化が図られたことで市販化に至っている(平成15年12月~現在)。消費は大部分を地元で占めるが、他県へ転居した人への贈答品としても利用され、根強い需要がある。中でも馬瀬さとやま株式会社(下呂市)の製造販売する製品(商品名:冬やわい)は、文化庁の100年フードに認定され(令和3年)、地域を代表する特産品となっている。
原料選択のポイント
“尾部を手で掴み、頭部を上に立つ”ほどに塩で締められたマスが良いとされるが、近年では低塩化された冷凍品しか入手できないため、これを解凍後に10%程度の食塩で締め直し、用途(ねずし,朴葉ずし等)に応じて塩抜きして用いる。塩締めの目的は、食中毒(ボツリヌス中毒)の予防と発酵熟成中の身崩れ防止のためであり、低塩分品をそのまま使用すると発酵によるpH低下で魚肉が締まらず身崩れしやすくなり、腐敗細菌の混入リスクも高まる。
加工技術
他のいずし類と同様、添加した米麹の各種酵素によりグルコース(甘味)とアミノ酸(うま味:グルタミン酸とアスパラギン酸)を生成させ、それらを原材料に付着した乳酸菌に利用させ、有機酸(酸味)の生成を狙ったものである。従って、米麹や野菜類等に加熱殺菌が施されることはなく、原料を汚染する腐敗細菌のリスクが常に潜在し、発酵不良による風味と呈味性の低下や腐敗、さらには食中毒による死亡事故さえも危惧しなければならない食品である。それゆえに安全性を確保する目的でpH調整剤などの添加物、酢酸、その他調味料(糖類、うま味調味料など)が多用され、結果的に乳酸菌の増殖さえも抑制してしまった製品も存在するようである。一方、岐阜県食品科学研究所では「ねずし」の品質劣化に関与する細菌群がそれぞれ異なる原料に由来した事実(バチルス属細菌は主に米麹、低温性グラム陰性細菌は主に野菜類)に基づき、抗菌スペクトルと生育温度帯の異なる2種の乳酸菌発酵スターターを使い分けた新規製造法(図1,2)を開発し、希望者に対して技術移転を行ってきた(図3)。本製法は、酸味料や添加物の使用を必要とせず、潜在する微生物学的リスクを解消し、「嗜好性の向上」、「品質の安定化」、「製造期間の短縮」を図るものである。なお、ナイシン生産性乳酸菌はサンエイラクトSMF-LL131としてサンエイ糖化株式会社より販売されており、低温性乳酸菌Lactobacillus sakei subsp. sakeiはHN-08株として岐阜県から有料頒布されている。

左;乳酸菌スターターによる新規製造法(<102/g)
右;伝統的な自然発酵による製造法(4.6×104/g)
製造工程の概略

加工の実際
低温性乳酸菌HN-08株を発酵スターターに用いたねずしの製造例を示す。
- 原料魚 塩マス(カラフトマスの塩蔵品)が用いられる。近年は低塩化された冷凍品がほとんどである。
- 塩漬け 解凍した塩マスの重量に対して10%の食塩を擦り込み、冷蔵で一週間程度塩蔵する。
- 塩抜き 塩蔵した塩マスを冷水に晒し、冷蔵で一晩塩抜きする。水量や時間を加減して好みの塩分(3%程度)に調整する。
- 下処理 塩マスを水洗し、三枚におろして皮を引き、2cm角の切り身にする。皮を付けたままの削ぎ身にする製造元もある。一樽仕込み分(1.5㎏)に小分けし、使用まで冷凍保管することもできる。
- 下漬け 本漬けの前日に大根・人参の下漬けを行う。皮を剥いた大根4㎏、人参400gを1×5cm程度の短冊切りにし、食塩100gを塗して重石をかけて冷蔵で一晩漬け込む。
- 水切り 野菜から出た上水を搾り、ザルに上げて水切りしておく。
- 本漬け 米2升を炊飯し、タライに上げて人肌程度まで冷ましておく(写真2)。これに大根・人参の浅漬け、塩マスの切り身1.5kg、米麹1㎏、生姜の微塵切り100gを加えて混合後、低温性乳酸菌HN-08株を約105/g接種し、良く混ぜ合わせて樽に漬け込む(写真3, 4)。
)写真②-1024x752.jpg)
(写真提供:馬瀬さとやま株式会社)
)写真③-1024x790.jpg)
(写真提供:馬瀬さとやま株式会社)
)写真④-1024x786.jpg)
(写真提供:馬瀬さとやま株式会社)
- 発酵・熟成 落し蓋と重石をかけ、冷蔵(5~10℃)で約7~10日間発酵させる。
- 包装 樽の表面に浮いた上水は取り除き、重石と落し蓋を取り除く(写真5)。薄手のポリ袋に秤取し、空気を抜いてバックシーラー等でポリ袋の口を封入する。
)写真⑤-1.jpg)
- 製品 透明なPET容器に入れ、製品ラベルを巻く(写真6)。賞味期限(開封前)は冷蔵(10℃以下)で2~3週間程度である。
)写真⑥-2.jpg)
加工に用いる機器等
発酵熟成庫(低温室もしくは業務用冷蔵庫)、製造用具一式(炊飯器,漬樽等)
※乳酸菌発酵スターターを用いることで1~2週間サイクルでの製造・出荷ができるため、製造量にもよるが大型の発酵熟成庫は必ずしも必要でなく、漬樽などは使い回すことができる。
品質管理のポイント
塩マスの切り身は1シーズンに製造する分をまとめて事前調製し、冷凍保管しておくと便利である。野菜類にはシュードモナス属などの低温性グラム陰性細菌が普遍的に存在し、それらの内部への侵入が少ない新鮮なものを使用する。米麹はバチルス属細菌~107/ g,マイクロコッカス104~6 /gなど主にグラム陽性細菌に汚染されたものが多く、その汚染度も様々である。特にバチルス属細菌は芽胞を形成するため良好に乳酸発酵しても最終製品の製造段階で死滅させることは困難であり、納豆臭やスモーク臭の発生原因になる可能性がある。よって、汚染度の低い米麹の利用、またナイシン生産性乳酸菌や低温性乳酸菌によるバイオプリザベーションを施し、汚染を低減させたものの使用が望まれる。なお、米麹はデンプンの老化防止のため冷蔵での保存・解凍は避け、冷凍保管して使用時に常温解凍することを推奨する。
製品の形態
薄手のポリエチレン系包材の袋に500gを詰めてバックシーラーでシールし、さらに透明なPET容器に入れてラベルを貼り付ける。また、発泡トレーに盛り付け、ラップで包装した製品もある。
包装および保管方法
上記のいずれの製品も冷蔵(10℃以下)で保管・流通され、賞味期限(開封前)は2~3週間程度である。
調理方法および食べ方
正月料理の一品として、酒の肴としてそのまま賞味される。
参考文献
・ 久田ら. 日本食品微生物学会誌, 1997, 14(2), 111.
・ 久田ら. 日本水産学会誌, 1998, 64(6), 1053.
・ 加島ら.日本食品科学工学会第49回大会講演集2002; 78.
・ 特許第4132037号:「乳酸発酵食品の製造方法」
・ 加島ら. 岐阜県製品技術研究所研究報告 No.4(2003)
・ 加島ら. 日本食品科学工学会第51回大会講演要旨集,2004
・ 加島. 日本食品科学工学会第56回大会講演集2009; 38.
(著者:岐阜県食品科学研究所 加島 隆洋)
